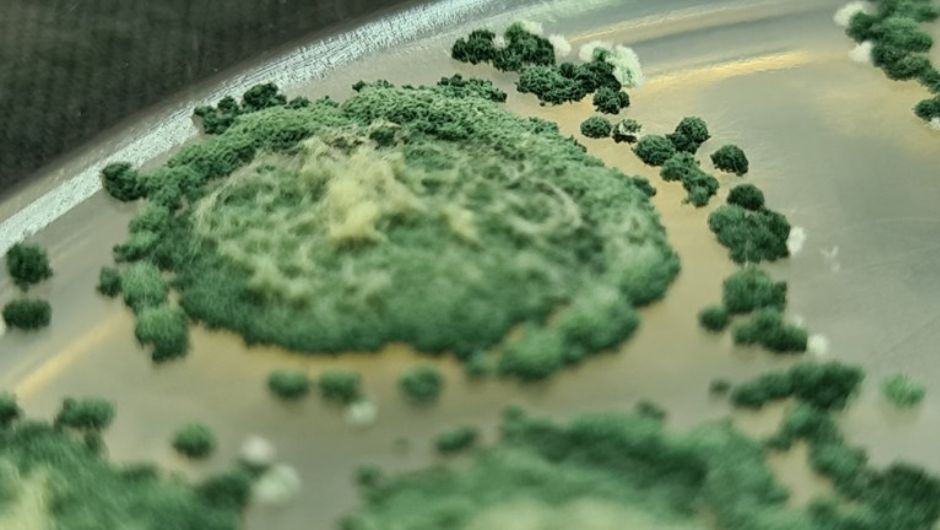

Mandioca BRS Jacundá promete triplicar produtividade no Amazonas
Cultivar será lançada em outubro em Manaus e pode fortalecer economia rural e segurança alimentar no estado
A Embrapa Meio Ambiente, em Jaguariúna (SP), realiza em 10 de outubro, das 8h45 às 12h, o Simpósio "Bioinsumos: Construindo o consórcio Holanda-Brasil para inovação", coordenado pelo pesquisador Wagner Bettiol e pelo analista Gabriel Mascarin, ambos da Embrapa Meio Ambiente, e pelo professor Flavio Medeiros da Universidade Federal de Lavras (UFLA).
O evento é promovido em parceria com a UFLA e a Wageningen University, por meio do Wageningen Plant Research. A iniciativa integra um projeto de um ano que busca mapear áreas de cooperação, reunir parceiros estratégicos e estruturar a formação de um consórcio voltado à elaboração de propostas conjuntas para projetos de maior porte nos próximos anos na área de bioinsumos.
Diante do avanço dos bioinsumos no Brasil e do fortalecimento da cooperação científica entre o país e a Europa, a Wageningen University articula a criação de uma rede de pesquisa voltada ao desenvolvimento de soluções macro e microbiológicas aplicadas ao biocontrole e a bioestimulantes em sistemas agrícolas. O simpósio oferecerá 200 vagas gratuitas para participantes.
A programação terá início com a abertura de Robson Barizon, chefe-adjunto de P&D da Embrapa Meio Ambiente. Das 9h30 às 9h45, Flavio de Medeiros (UFLA) discutirá o tema “Biocontrole ou bioestimulante? Faz sentido desconsiderar o potencial de um bioestimulante microbiano?”. Logo depois, Gabriel Mascarin apresentará avanços na produção de agentes de biocontrole. A manhã segue com um café interativo para estimular a troca de experiências entre os participantes.
No período seguinte, Rodrigo Mendes da Embrapa Meio Ambiente destacará a aplicação do microbioma no controle de problemas fitossanitários; Emanuele Diniz da Vigna abordará o processo de registro de agentes de biocontrole no Brasil. A pauta também inclui a palestra de José Eduardo Marcondes (Instituto Biológico), que tratará da importância da especificação de referência para o avanço do controle biológico no país; e a palestra do Marcos Faria da Embrapa Recursos Genéticos e Biotecnologia, que discutirá a legislação brasileira relacionada aos bioinsumos.
Após as palestras ocorrerá uma sessão coordenada por Wagner Bettiol, onde todos poderão participar nas discussões sobre o que se espera do futuro dos bioinsumos no Brasil.
Para Flávio Medeiros da UFLA, hoje há mais de um caminho regulatório para se registrar um bioinsumo, seja como inoculante ou como biodefensivo. “No entanto, acredita ele, é comum encontrarmos microrganismos que proporcionam mais de um beneficio para a planta, podem atuar em ambas as funções, por exemplo promovendo o enraizamento de plantas, mas também controlando doenças, ou seja, a empresa tem que fazer escolha de uma das vias de registro para comercializar seu produto e, independente da via escolhida, não serão contemplados todos os benefícios de adoção da tecnologia, um conceito que apresento como armadilha regulatória”, avalia.
“No evento, apresentaremos diversos cenários que imposição regulatória pode limitar o benefício que um bioinsumo microbiano possui e quais as implicações desta armadilha regulatória para o desenvolvimento de plantas e custo de produção”, destaca.
De acordo com Bettiol, para o Brasil se manter líder na produção e consumo de bioagentes há necessidade de um grande investimento em pesquisas e treinamentos, sendo esse projeto uma grande oportunidade para aperfeiçoarmos tanto as nossas pesquisas, como os treinamentos em bioinsumos no Brasil, pois tem potencial de reunir parceiros estratégicos de diversas partes do mundo.

Receba por e-mail as últimas notícias sobre agricultura